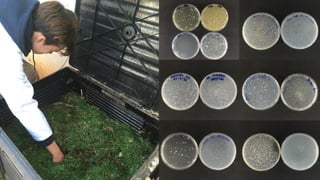
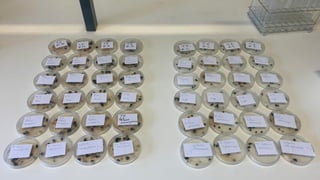

Este documento describe el proyecto "BICHOCOMPO: Analizando la biodiversidad de invertebrados en una pila de compost", que forma parte de los proyectos de ciencia ciudadana CAOS. El objetivo es identificar la mesofauna que aparece en pilas de compostaje para proponerlos como bioindicadores de la calidad del compost. Los estudiantes realizarán muestreos de invertebrados y compost, identificarán los invertebrados, y analizarán las propiedades del compost como parte de la investigación. Los resultados se presentarán